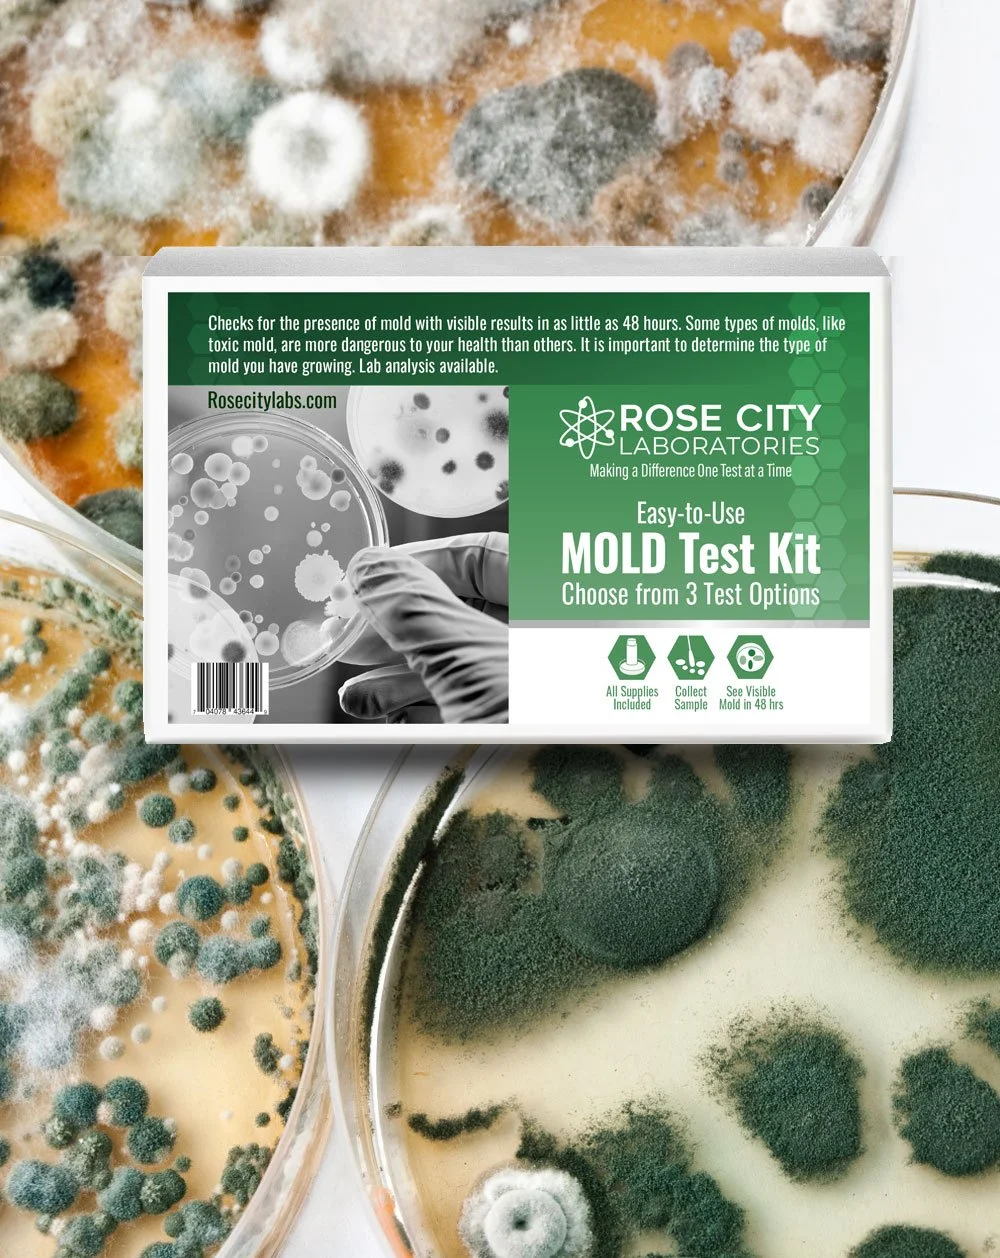
Mold_Surface-FR.jpg

NEWSLETTER
VOL. 03 | DECEMBER 31 . 2025
A LOOK Back

Rose City Labs
It was another year of excited growth and change at the lab. New certifications In ASSE Legionella, Lead inspection and AMMI, expands our capabilities in many categories. We held our first sold out workshop for psilocybin facilitators, sponsored two Portland Pickles games, including Science night. We sponsored a few seminars on Legionella, and probably the biggest Lab announcement was our co-authored publication in JAMA. There were some amazing personnel additions as well as a few departures, but overall growth in every category.
As we usher in the new year, let's take a glimpse at the highlights of the past year…